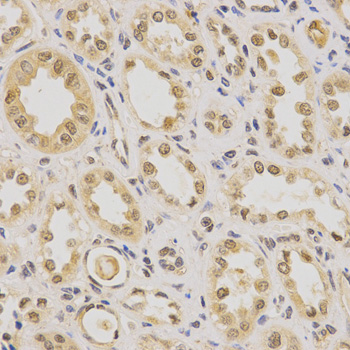
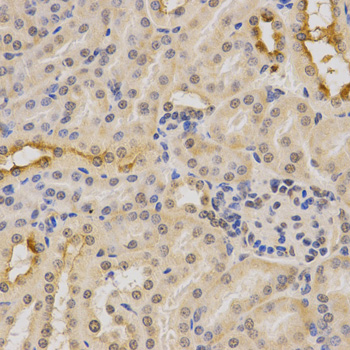

For quotations, please use our online quotation form, and you may also contact us by
service@kendallscientific.com
+1-888.733.6849 (Toll-free)
+1-617.299.7367 (Int’l))
+1-888.733.6849
Our customer service representatives are available 24 hours, Monday through Friday to assist you.| Reactivity | Human Mouse Rat |
| Tested applications | WB IHC IF |
| Recommended Dilution | WB 1:500 - 1:2000 IHC 1:50 - 1:200 IF 1:50 - 1:200 |
| Calculated MW | 43kDa |
| Observed MW | Refer to Figures |
| Immunogen | Recombinant protein of human PDHA1 |
| Storage Buffer | Store at -20℃. Avoid freeze / thaw cycles. Buffer: PBS with 0.02% sodium azide, 50% glycerol, pH7.3. |
| Synonym | PDHA; PDHCE1A; PHE1A; |

Western blot analysis of extracts of various cell lines, using PDHA1 antibody.
Immunohistochemistry of paraffin-embedded human kidney using PDHA1 antibody at dilution of 1:200 (x400 lens).
Immunohistochemistry of paraffin-embedded mouse kidney using PDHA1 antibody at dilution of 1:200 (x400 lens).

Immunofluorescence analysis of U2OS cell using PDHA1 antibody. Blue: DAPI for nuclear staining.

Immunofluorescence analysis of U2OS cell using PDHA1 antibody. Blue: DAPI for nuclear staining.
The pyruvate dehydrogenase complex catalyzes the conversion of pyruvate and CoA into acetyl-CoA and CO2 in the presence of NAD+. Acetyl-CoA then goes into the citric acid cycle where it reacts with oxaloacetate to form citrate. Acetyl-CoA is also used for fatty acid and cholesterol biosynthesis. The reaction of oxidative decarboxylation of pyruvate therefore serves as a critical link between glycolysis and the citric acid cycle and lipid metabolism. In mammalian cells, the pyruvate dehydrogenase complex is located in the mitochondrial matrix (1). This complex is comprised of three enzymes: pyruvate dehydrogenase (E1), dihydrolipoamide acetyltransferase (E2) and dihydrolipoamide dehydrogenase (E3). Pyruvate dehydrogenase (E1) consists of two subunits: α and β. This enzyme catalyzes the removal of CO2 from pyruvate. Mutations in the α subunits of pyruvate dehydrogenase (E1) lead to congenital defects that are usually associated with lactic acidosis, neurodegeneration and early death (2).
N/A